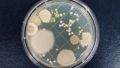

排水口から聞こえるボコボコ音は、日常生活においてかなり不快なものです。この記事では、その原因と対処法について詳しく説明します。快適な生活のために、排水口のトラブルに早めに対処しましょう。
排水口ボコボコ音の主な原因
排水口から聞こえるボコボコ音は、一般的に水の流れや排水管内の状態に起因しています。これらの要因を詳しく見ていきましょう。
水流と空気の相互作用
排水口から水が流れる際、水と空気が相互作用することが音の原因となります。
水が急激に流れたり、水流が管内で変化したりすると、気泡や空気が発生し、それがボコボコ音として聞こえることがあります。
この現象は、特に水流の速さや排水口の形状に影響を受けます。例えば、たくさんの水を一気に流すとこういった現象が起こることが多いです。
排水管内の異物やゴミ
排水口やパイプ内に溜まったヘア、石鹸のかけら、食べカスなどの異物やゴミが、水流を妨げる要因となります。
これにより水が流れる際に抵抗が生じ、ボコボコ音が発生することがあります。
特に、排水口の掃除や定期的なメンテナンスを怠っていると、問題が蓄積しやすくなります。
排水口の構造に起因する問題
排水口やパイプの設計に欠陥がある場合、水流が乱れ、それがボコボコ音の原因となります。
排水口の形状やパイプの角度が不適切であったり、設置が正しく行われていなかったりすると、水の流れが安定せず、異音が発生します。
特に新しい住宅や設備の場合、施工不良が原因となることがあります。
または、排管の劣化や地震等によっても、排水管がズレたり破損する場合があり、こういった現象に繋がることがあります。
これらの原因を理解することは、ボコボコ音に対処する第一歩です。これらの原因に対する具体的な対策や改善方法について掘り下げていきます。
ボコボコ音の対処法
排水口からのボコボコ音が気になる場合、具体的な解消方法と予防策について考えていきましょう。
水の流れを調整する
ボコボコ音の原因となる一つは、水流の急激な変化です。これを緩和するために、水の流れを調整することが重要です。
具体的な方法として、蛇口や水栓をゆっくりと開けたり閉めたりすることで、水流の安定化を図ることができます。
もしくは、水圧が強すぎることによるウォーターハンマー現象が起こっている場合などには、止水栓や単水栓を調節し、水量を調整することで防げることもあります。
排水口の定期的な掃除
排水口やパイプ内にたまったヘアやゴミが水流を妨げ、異音の原因となります。
定期的な掃除を怠らず、ヘアキャッチャーを利用することで、異物の蓄積を防ぎましょう。
特に、キッチンの排水口では食べカスや脂が原因となることが多いため、こまめな清掃が必要です。
また、フライパンやお皿の油などは事前に拭き取ってから洗うなど、なるべく原因となるものを流さないようにする工夫も有効です。
排水口に50℃くらいのお湯を流し込む
手軽に行えて一定の効果が期待できるのは、バケツ一杯程度の50℃程のお湯を流し込む方法です。
軽度の油などの汚れであれば、柔らかくして流れやすくなります。
注意点としては、排水口のゴミ受けのゴミは取り除いてから流してください。
また、60℃以上など熱すぎると、排水管の変形などに繋がることがあるため注意が必要です。
排水管専用の薬剤を使用する
パイプ用洗浄剤を流すことで中に溜まった汚れを洗浄します。
汚れの蓄積が原因でボコボコ音がなっている場合には、効果的です。
使い方は使用する洗浄剤の方法に従ってください。最近は、粘性の高いものも多く、使い方を誤るとさらなる悪化を招くこともあります。
ワイヤーブラシなど道具を使って汚れを直接取り除く
ワイヤーブラシで汚れを取り除く方法もあります。
ただし、大きい汚れを大まかに取るには向いていますが、細かな汚れまでは除去しきれないことがあります。
また、先が金属製になっているものは、排水管を傷つけてしまう可能性もあり、傷がつくとそこにヌメリや汚れが蓄積されやすくなるため使用には注意が必要です。
排水管の専門家に相談
ボコボコ音が解消できない場合、排水管に問題がある可能性があります。
このような場合は、専門家に相談し、排水管の検査や修理を行うことが重要です。
施工ミスや老朽化が原因である場合も少なからずありますので、専門的な診断が必要です。
設備の適切な取り付け
新しい設備や排水口を取り付ける際には、適切な方法で施工することが重要です。正確な角度や設置方法を守り、設計通りに取り付けることで、ボコボコ音を予防することができます。
振動を吸収するパッドの設置
リフォームやリノベーションを検討されている場合には、排水管の防振パッドを取り付けることで音の解消に繋がることもあります。
DIY修理の注意点
ボコボコ音が自分で解決できそうな場合でも、DIY修理には注意が必要です。設備の構造や排水管の特性を理解せずに行うと、問題を悪化させる可能性があります。簡単な修理で解消できない場合は、専門家の助言を仰ぐことをおすすめします。
これらの対策を実践することで、排水口からのボコボコ音を軽減し、快適な生活環境を維持することができます。
まとめ
排水口から聞こえるボコボコ音は、単なる音の問題だけでなく、排水設備のトラブルのサインかもしれません。
そのような場合には、早めの対処が重要です。日常的なメンテナンスや対策を行いつつ、時にはプロの助けを借りることが大切です。

コメント